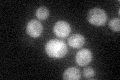
YMR165C
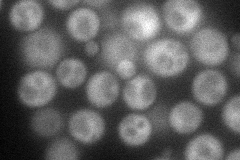
YMR165C
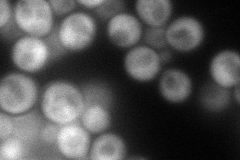
YMR165C
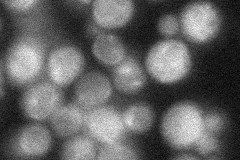
YMR165C
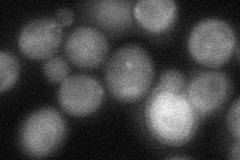
YMR165C
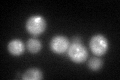
YMR165C
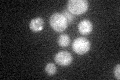
YMR165C

View description
Mg<sup>2+</sup>-dependent phosphatidate (PA) phosphatase, catalyzes the dephosphorylation of PA to yield diacylglycerol and P<sub>i</sub>, responsible for de novo lipid synthesis; homologous to mammalian lipin 1
Localization:
Intensity:
Fold change:
Significance:
-
C’ GFP library in SD
cytosol33.13 -
N' NOP1pr-GFP in SD
cytosol78.3306 -
N' TEF2pr-mCherry in SD
cytosol101.262 -
N' NATIVEpr-GFP in SD
below threshold28.4663 -
N' TEF2pr-VC and Cyto-VN in SD
cytosol44.0196 -
C’ GFP library in SD+DTT
cytosol42.221.27No -
C’ GFP library in SD+H2O2

cytosol31.180.94No -
C’ GFP library in Starvation Media
cytosol37.341.12No -
C’ GFP library on the background of Pup2-DaMP

N/A -
C’ GFP library on the background of CCT mutant

N/A0N/AYes
